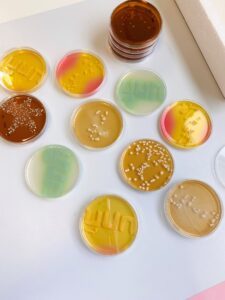

ΤΙ ΕΙΝΑΙ ΤΟ ΜΙΚΡΟΒΙΩΜΑ;
Το μικρoβίωμα μας είναι το σύνολο των μικροοργανισμών (βακτήρια, ιοί, μύκητες) που κατοικούν στο σώμα μας. Ο αριθμός τους είναι της τάξεως των δισεκατομμυρίων. Σε μεγάλη συγκέντρωση βρίσκονται κυρίως στο έντερο, στο δέρμα, στο στόμα, στη μύτη κά. Το μικροβίωμα είναι ξεχωριστό για κάθε άνθρωπο και το πρώτο του αποτύπωμα το λαμβάνουμε κατά τη γέννηση μας από τη μητέρα μας. Στην φυσιολογική κατάσταση το μικροβίωμα αποτελείται από φιλικά βακτήρια που συνυπάρχουν με τα παθογόνα, αλλά σε συγκεντρώσεις μεταξύ τους, που επιτρέπουν την συμβίωση τους και αυτή η συμβίωση συμβάλλει στην υγεία του σώματος. Όταν η συμβίωση αυτή διαταραχθεί, για παράδειγμα στο δέρμα, αυτό έχει επίπτωση, σε καταστάσεις όπως η Ακμή, η Ατοπία, η Ροδοχρους κλπ.
Το ανθρώπινο μικροβίωμα επηρεάζεται από εξωγενείς, περιβαλλοντικούς παράγοντες, όπως ο καιρός, η θερμοκρασία, η χρήση χημικών, η τροφή και ενώ μπορεί να επηρεαστεί με αρνητικό τρόπο από το περιβάλλον και να έρθει σε κατάσταση ανισορροπίας, μπορεί να επηρεαστεί και με θετικό και η ανισορροπία να μετατραπεί σε συμβίωση. Σε αυτό βοηθούν τα Προβιοτικά και ακόμα περισσότερο τα ΕΝΕΡΓΑ ΠΡΟΒΙΟΤΙΚΑ.
Η τοπική χρήση προβιοτικών προϊόντων για το δέρμα, έχει αποδειχθεί ότι βοηθάει στην υγεία του δέρματος και προλαμβάνει, σε συνδυασμό ή όχι, καταστάσεις όπως η Ακμή, η Ατοπία, η Ροδόχρους, οι Μυκητιάσεις, η Γήρανση του δέρματος.
ΤΑ ΒΑΚ(ΤΗΡΙΑ) ΜΑΣ ΜΠΟΡΟΥΝ